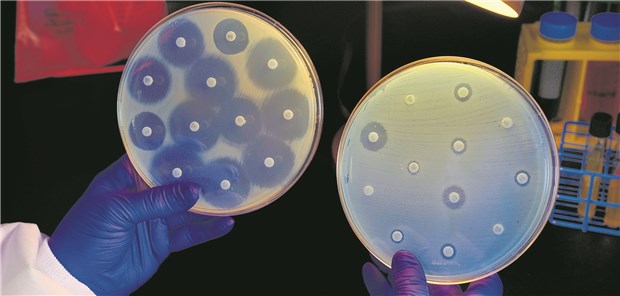

Gefährlich
Beta-Laktam-Resistenz als Reisemitbringsel
Beta-Laktam-Antibiotika drohen durch das Einschleppen von Enterobakterien, die Träger der Extended-Spectrum-Betalaktamase (ESBL) sind, ihre Wirkung zu verlieren.
Veröffentlicht:
Nach der Rückkehr von einer Fernreise bleiben ESBL-Keime oft noch monatelang im Darm nachweisbar.
© CDC / James Gathany
BERLIN. Experten der Deutschen Gesellschaft für Gastroenterologie, Verdauungs- und Stoffwechselerkrankungen (DGVS) haben vor dem Import von Beta-Laktam-Resistenzen durch Fernreisende gewarnt.
Verantwortlich für dieses Risiko seien Enterobakterien, die Träger der Extended-Spectrum-Betalaktamase (ESBL) sind. ESBL könne praktisch sämtliche Beta-Laktam-Antibiotika wie Penicilline und Cephalosporine abbauen.
Damit drohten die entsprechenden Antibiotika ihre Wirkung zu verlieren. Beta-Laktam-Antibiotika seien in Europa von erheblicher Bedeutung, unter anderem zur Behandlung von Escherichia coli-(E. coli)-Infektionen.
Speziell Fernreisen in Regionen mit hohen Zahlen von ESBL-Trägern seien risikobehaftet, berichtete Professor Andreas Stallmach vom Universitätsklinikum Jena.
Zu diesen zählten Südostasien mit 1,1 Milliarden ESBL-Trägern, gefolgt von den westpazifischen Staaten, dem vorderen Orient und Afrika mit zusammen 110 Millionen Betroffenen. In Amerika und Europa lebten rund 35 Millionen Träger von Bakterien mit ESBL-Resistenzgen.
Hohe Durchseuchung in Südostasien
Als Ursache der hohen Durchseuchung in Südostasien würden ungenügender Zugang zu sauberem Trinkwasser und verbreitete Armut in Kombination mit einer hohen Bevölkerungsdichte vermutet.
Unter derartigen Bedingungen fänden ESBL-Resistenzgene besonders gute Möglichkeiten vor, sich über fäkal-orale Infektionswege zu verbreiten.
Fernreisende könnten insbesondere unter hygienisch eingeschränkten Bedingungen ("Rucksacktourismus") von ESBL-Keimen kolonisiert werden. Durchfallerkrankungen und die Einnahme von Antibiotika erhöhten das Risiko für die Kolonisierung auf bis zu 85 Prozent.
Nach der Rückkehr blieben die ESBL-Keime teilweise noch monatelang im Darm nachweisbar und könnten eine Gefahr für Kranke oder immungeschwächte Personen darstellen.
Inzwischen mehrten sich Studien, die die einschlägigen Veränderungen des Mikrobioms unter anderem auf Fernreisen beschrieben.
Tagtägliche Veränderung des Mikrobioms
Stallmach hob dabei besonders eine Untersuchung aus dem Jahr 2014 hervor, die anhand von mehr als 10.000 Analysen die tagtäglichen Veränderungen des Mikrobioms zweier Probanden über den Verlauf eines Jahres beschrieben habe (Genome Biology 2014; 15: R89).
Zwar hätte die Studie einerseits eine hohe und langfristige Stabilität des Mikrobioms nachgewiesen, ebenso jedoch auch die deutlichen Veränderungen, die mit einem Wechsel der Lebensgewohnheiten verbunden gewesen seien.
So habe die Fernreise eines der beiden Teilnehmer in ein weniger entwickeltes Land in seinem Mikrobiom unmittelbar zu einer Verschiebung des Verhältnisses von Bacteroides- zu Firmicutes-Spezies geführt. Nach der Rückkehr habe sich das Verhältnis wieder zum Ausgangszustand zurück entwickelt.
Ganz allgemein stellen der Darm und sein Mikrobiom ein zentrales Interaktionszentrum mit der Umwelt dar. 23.000 menschliche Gene begegnen dort 5 bis 8 Millionen mikrobiellen.
Das Mikrobiom beeinflusst neben Darm- und Lebererkrankungen nachweislich auch Adipositas, Diabetes mellitus, Malignome, Alzheimer und Parkinson. Tatsachen, die weitere Forschung auf diesem Gebiet unverzichtbar erscheinen lassen.